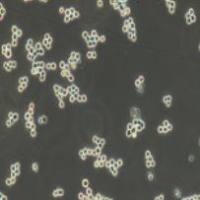
RAMOS 人B淋巴细胞瘤细胞

相关产品推荐更多 >
万千商家帮你免费找货
0 人在求购买到急需产品
- 详细信息
- 技术资料
- 英文名:
LLC
- 库存:
24
- 细胞形态:
上皮细胞样
- 运输方式:
常温运输/干冰运输
- 年限:
详见说明书
- 生长状态:
贴壁
- 规格:
株
产品名称:小鼠lewis肺癌细胞
产品规格:1 x 10^6 cells/T25培养瓶
产品价格:请与我司取得联系
小鼠lewis肺癌细胞特性
1)来源:JCRB
2)形态:贴壁
3) 种属:小鼠
4)含量:>1x10^6个/mL
5)污染:支原体、细菌、酵母和真菌检测为阴性
6)规格:T25瓶或者1mL冻存管包装
客户收到小鼠lewis肺癌细胞后需要注意的事项:
1)请先检查是否有漏液或者污染情况,若发现漏液或者污染,请拍照发给我们,我们核实后会进行退换。
2)请先放置于显微镜下观察细胞生长状态,撕去封口膜并将瓶子置于37℃培养约2-3个小时。
3)弃去瓶中的培养基,添加6ml本公司附带的完全培养基。
4)如果细胞长满到90%以上,就要及时进行细胞传代,传代培养用6ml本公司附带的完全培养基。
我司还提供:
产品规格:1 x 10^6 cells/T25培养瓶
产品价格:请与我司取得联系
小鼠lewis肺癌细胞特性
1)来源:JCRB
2)形态:贴壁
3) 种属:小鼠
4)含量:>1x10^6个/mL
5)污染:支原体、细菌、酵母和真菌检测为阴性
6)规格:T25瓶或者1mL冻存管包装
客户收到小鼠lewis肺癌细胞后需要注意的事项:
1)请先检查是否有漏液或者污染情况,若发现漏液或者污染,请拍照发给我们,我们核实后会进行退换。
2)请先放置于显微镜下观察细胞生长状态,撕去封口膜并将瓶子置于37℃培养约2-3个小时。
3)弃去瓶中的培养基,添加6ml本公司附带的完全培养基。
4)如果细胞长满到90%以上,就要及时进行细胞传代,传代培养用6ml本公司附带的完全培养基。
我司还提供:
| 人T细胞性白血病细胞 |
| 永生化人脑微血管内皮细胞 |
| 人胰腺癌细胞 |
| 人绒毛膜癌细胞 |
| 人胰腺癌细胞 |
| 人神经母细胞瘤细胞 |
| 人T淋巴瘤白血病细 |
| 人皮肤黑色素瘤细胞 |
| 人肝癌细胞 |
| 人微血管內皮細胞株 |
风险提示:丁香通仅作为第三方平台,为商家信息发布提供平台空间。用户咨询产品时请注意保护个人信息及财产安全,合理判断,谨慎选购商品,商家和用户对交易行为负责。对于医疗器械类产品,请先查证核实企业经营资质和医疗器械产品注册证情况。
技术资料暂无技术资料 索取技术资料
小鼠lewis肺癌细胞
¥600 - 2680